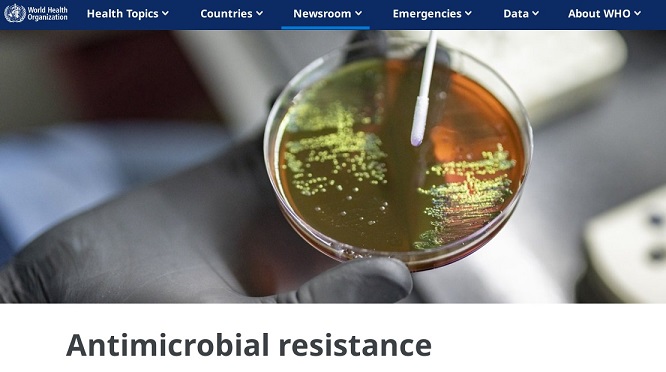

31 ธันวาคม 2566
แปลและเรียบเรียงบทความโดย: อดิศร สุขสมอรรถ
ตรวจทานและพิสูจน์อักษร : คมส์ธนนท์ ศุขอัจจะสกุล
ข้อมูลที่ถูกแชร์ :
มีข้อมูลเท็จเผยแพร่ทางสื่อสังคมออนไลน์ในไต้หวัน ที่อ้างว่าการแพร่ระบาดของโรคปอดอักเสบในสาธารณรัฐประชาชนจีนที่เกิดจากเชื้อแบคทีเรีย Mycoplasma Pneumoniae ส่งผลให้ยาปฏิชีวนะ Azithromycin ขาดตลาดในไต้หวัน เนื่องจากผู้คนต่างหันมากักตุนยาปฏิชีวนะเพื่อรับมือการแพร่ระบาดของโรคปอดอักเสบที่เกิดจากเชื้อแบคทีเรียนี้

บทสรุป :
Azithromycin เป็นยาตามใบสั่งแพทย์ คนไข้ไม่ควรซื้อยากินเอง เพราะการใช้ยาอย่างผิดวิธี อาจทำให้เกิดปัญหาเชื้อโรคดื้อยาในอนาคต
FACT CHECK : ตรวจสอบข้อเท็จจริง :

Azithromycin (อะซิโทรมัยซิน) เป็นยาปฏิชีวนะที่ใช้รักษาอาการติดเชื้อจากแบคทีเรีย เช่น โรคปอดอักเสบ โรคหลอดลมอักเสบ ทอนซิลอักเสบ ไซนัสอักเสบ รวมถึงโรคติดต่อทางเพศสัมพันธ์ เช่น หนองใน โดยยาจะออกฤทธิ์ยับยั้งการเจริญเติบโตของเชื้อแบคทีเรีย
จากการสอบถามความเห็นผู้เชี่ยวชาญโดย Taiwan FactCheck Center พบว่า ยาปฏิชีวนะ Azithromycin ในไต้หวันยังมีอย่างพอเพียงต่อการรับมือการแพร่ระบาดของโรคระบบทางเดินหายใจในฤดูหนาว หากเกิดการขาดแคลนยา Azithromycin ขึ้นจริง ก็ยังมียาปฏิชีวนะชนิดอื่น ๆ ที่สามารถใช้ทดแทนได้
อย่างไรก็ดี โรคปอดอักเสบที่พบการระบาดในจีน ผู้ป่วยส่วนใหญ่มีอาการไม่รุนแรง หลายรายสามารถรักษาให้หายขาดโดยไม่จำเป็นต้องใช้ยาปฏิชีวนะ
ส่วนการอ้างว่าเกิดกระแสกักตุนยา Azithromycin จนขาดตลาดก็ไม่น่าจะเป็นความจริง เพราะยา Azithromycin ยาตามใบสั่งแพทย์ ผู้ป่วยไม่ควรชื้อยา Azithromycin มาใช้เอง เพราะยา Azithromycin ต้องใช้ตามคำแนะนำของแพทย์และเภสัชกรอย่างเคร่งครัด ไม่ควรใช้ยาในปริมาณที่มากหรือน้อยกว่าที่กำหนด เนื่องจากปริมาณการใช้ยา Azithromycin จะแตกต่างกันไปในผู้ป่วยแต่ละคน ขึ้นอยู่กับอายุ จุดประสงค์การรักษา และดุลยพินิจของแพทย์ และไม่ควรหยุดยาเองโดยไม่ปรึกษาแพทย์
การกักตุนยา Azithromycin เพื่อนำไปใช้เองจึงเป็นเรื่องต้องห้าม เพราะการใช้ยาปฏิชีวนะอย่างไม่ถูกต้อง อาจนำไปสู่ปัญหาการดื้อยาในอนาคต
หน่วยงานสาธารณสุขของสาธารณรัฐประชาชนจีนประเมินว่า ปัญหาการดื้อยาของเชื้อโรค (Antimicrobial Resistance : AMR) กำลังเพิ่มมากขึ้นในประเทศ ส่วนในไต้หวันก็พบว่าปัญหาการดื้อยาของเชื้อโรคเพิ่มขึ้นจากปีก่อนถึง 60%
งานวิจัยระหว่างปี 2017-2019 พบว่า มีผู้ป่วยโรคปอดอักเสบจากเชื้อแบคทีเรียถึง 77% ที่มีอาการดื้อยาต่อยาปฏิชีวนะสูตรแรก (First-Line Antibiotics) ซึ่งสาเหตุหลักมาจากการใช้ยาปฏิชีวนะอย่างไม่ถูกต้อง ผู้ป่วยบางรายใช้ยาปฏิชีวนะรักษาอาการไอมานานแต่อาการไม่ดีขึ้น แสดงให้เห็นว่าสาเหตุของโรคอาจไม่ได้เกิดจากแบคทีเรีย ซึ่งการใช้ยาผิดประเภทนอกจากไม่ช่วยให้หายจากโรคแล้ว ผู้ป่วยยังได้รับผลเสียจากการใช้ยาอย่างผิดประเภทอีกด้วย
การใช้ยาปฏิชีวนะอย่างผิดวิธี อาจทำให้ปัญหาการดื้อยาของเชื้อโรคเพิ่มสูงขึ้น และส่งผลให้จำนวนยาที่สามารถใช้รักษาผู้ป่วยลดลงในอนาคตเช่นกัน


ข้อมูลอ้างอิง :
https://tfc-taiwan.org.tw/articles/9957
หากได้รับอะไรมา อย่าเพิ่งแชร์ต่อ ส่งมาตรวจสอบกับ “ศูนย์ชัวร์ก่อนแชร์”
LINE :: @SureAndShare หรือคลิก http://line.sure.guru
FB :: https://www.facebook.com/SureAndShare
YouTube :: https://www.youtube.com/@SureAndShare
Twitter :: https://www.twitter.com/SureAndShare
IG :: https://instagram.com/SureAndShare
Website :: http://www.ชัวร์ก่อนแชร์.com
TikTok :: https://www.tiktok.com/@sureandshare
สมัครรับฟรี ชัวร์ก่อนแชร์ Newsletter ส่งถึงกล่องอีเมลของคุณทุกสัปดาห์ :: https://i.sure.guru/sureandshareNewsletter